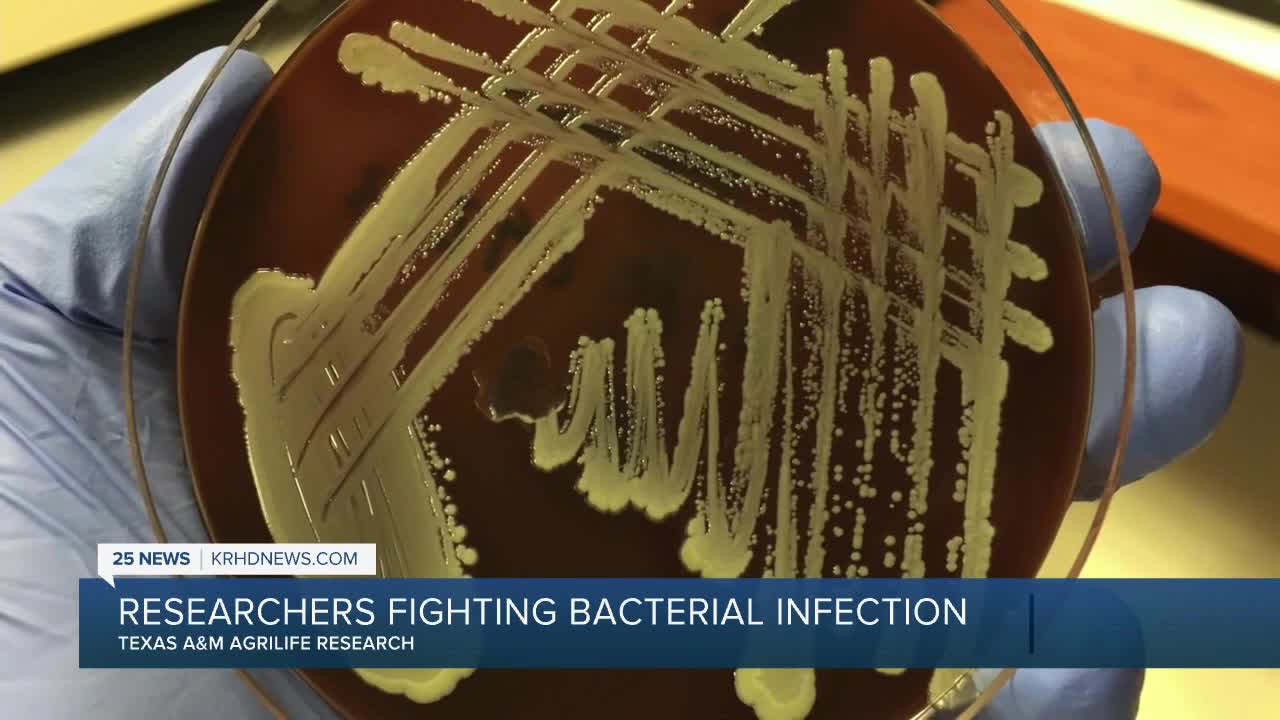

COLLEGE STATION, TX — The national institute of allergy and infectious diseases is supporting researchers at Texas A&M in their fight against bacterial infections.
Niaid awarded the school's AgriLife research nearly $400,000 in grants for their findings on bacteriophage therapy, which researchers think, could yield novel ways to fight antimicrobial-resistant bacteria.
The grant, which provides two years of funding, will be used to address key knowledge gaps in the development of phages as preventive and therapeutic tools for bacterial infections.
"We started this project by looking at this infection, the phage infection. We want to look at the fundamental mechanism, it kind of detach the pili," said Lanying Zeng, Texas A&M Associate Professor with the Department of Biochemistry and Biophysics.
2019 centers for disease control and prevention report revealed that anti-biotic resistant pathogens caused more than nearly 3,000,000 infections and close to 35,000 deaths annually in the U.S.
“LIKE” 25 NEWS KRHD ON FACEBOOK FOR ALL THE LATEST BRAZOS VALLEY STORIES